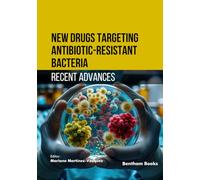
New Drugs Targeting Antibiotic-Resistant Bacteria: Recent Advances

Recent Advances in Materials and Manufacturing Science: Select Proceedings of Icram 2025
Pubblicità

Recent Advances in Materials and Manufacturing Science: Select Proceedings of Icram 2025
213,99 €
Spedizione gratuita
Recent Advances in Materials and Manufacturing Science: Select Proceedings of Icram 2025

Prezzo totale più basso
Attualmente non disponibile. Questo articolo non è al momento disponibile ma può diventarlo in futuro. Puoi effettuare l'ordine ora: ti avviseremo non appena avremo maggiori informazioni. Disponibile consegna express con Amazon Prime.
Addebito in c/c
Addebito in c/c
Visa
Visa
Mastercard
Mastercard
213,99 €
Spedizione gratuita
Recent Advances in Materials and Manufacturing Science: Select Proceedings of Icram 2025

Generalmente spedito entro 6 settimane. Disponibile consegna express con Amazon Prime.
Addebito in c/c
Addebito in c/c
Visa
Visa
Mastercard
Mastercard
215,26 €
Spedizione gratuita
🤖 Chiedi a ChatGPT
💡 Ne vale la pena?
🔁 Ci sono alternative migliori?
⭐ Cosa ne pensano gli utenti?
Recent Advances in Materials and Manufacturing Science: Select Proceedings of Icram 2025 - Dettagli
▶ Trova sempre il prezzo più conveniente!
Abbiamo trovato 2 prezzi per Recent Advances in Materials and Manufacturing Science: Select Proceedings of Icram 2025 La nostra lista dei prezzi è sempre trasparente e visualizzata in ordine crescente di prezzo. Possono aggiungersi costi di spedizione.
Recent Advances in Materials and Manufacturing Science: Select Proceedings of Icram 2025 - Informazioni sul prezzo
- Prezzo più basso: 213,99 €
- Il prezzo più basso è offerto dallo shop Amazon.it . Lì puoi effettuare l'ordine per l'offerto.
- Con un totale di 2 offerte, la variazione di prezzo per Recent Advances in Materials and Manufacturing Science: Select Proceedings of Icram 2025 oscilla tra 213,99 €€ - 215,26 €€.
- Metodi di pagamento: Amazon.it accetta Addebito in c/c, Visa, Mastercard.
- Consegna: il tempo di consegna più veloci è offerto dallo shop Amazon.it con Attualmente non disponibile. Questo articolo non è al momento disponibile ma può diventarlo in futuro. Puoi effettuare l'ordine ora: ti avviseremo non appena avremo maggiori informazioni. Disponibile consegna express con Amazon Prime. giorni lavorativi.
Prodotti simili

43,67 €
amazon-marketplace.it
Spedizione gratuita

90,39 €
Amazon.it
Spedizione gratuita

213,99 €
Amazon.it
Spedizione gratuita

140,40 €
Amazon.it
Spedizione gratuita
78,41 €
Amazon.it
Spedizione gratuita
Non dimenticarti del tuo codice sconto:
Segnala violazione
State per segnalare una violazione legale sulla base della Legge sui servizi digitali dell'UE.